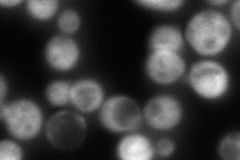
YJL130C
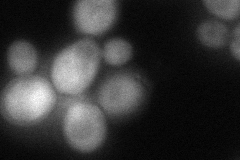
YJL130C
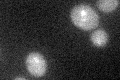
YJL130C
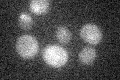
YJL130C

View description
Bifunctional carbamoylphosphate synthetase (CPSase)-aspartate transcarbamylase (ATCase), catalyzes the first two enzymatic steps in the de novo biosynthesis of pyrimidines; both activities are subject to feedback inhibition by UTP
Localization:
Intensity:
Fold change:
Significance:
-
C’ GFP library in SD

below threshold20.16 -
N' NOP1pr-GFP in SD

cytosol431.352 -
N' TEF2pr-mCherry in SD

cytosol53.0631 -
N' NATIVEpr-GFP in SD
cytosol169.682 -
N' TEF2pr-VC and Cyto-VN in SD
cytosol87.5715 -
C’ GFP library in SD+DTT
cytosol17.490.86No -
C’ GFP library in SD+H2O2

cytosol23.821.18No -
C’ GFP library in Starvation Media
cytosolN/AN/AYes -
C’ GFP library on the background of Pup2-DaMP

below threshold -
C’ GFP library on the background of CCT mutant

below threshold19.28430.956083No
